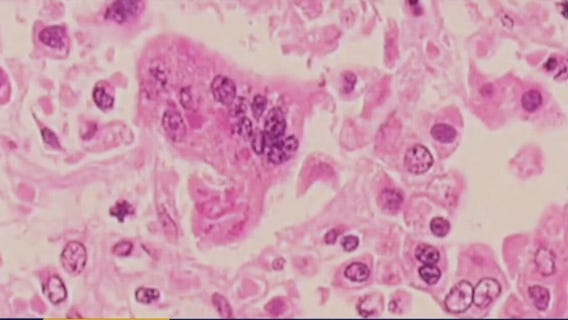
Possible measles cases in San Marcos, San Antonio

Texas Medical Board increases transparency for Botox treatments
The Texas Medical Board has tightened transparency regulations on clinics that perform Botox and hydration therapies.
Victory Lap awareness walk in Houston this Saturday to fight colon cancer
Everyone in the Greater Houston area is invited to join the event to not only show their support for colon cancer awareness but to engage in meaningful conversations about the importance of health screenings.
Texas Measles outbreak 2025: 124 cases identified
A measles outbreak in Texas continues to grow. State health officials say the outbreak is the largest in the state in nearly 30 years.
San Antonio warns of possible measles exposure
The City of San Antonio is warning residents about a potential exposure to measles at UT San Antonio and the Riverwalk earlier this month.
Measles: Hays County warns of possible exposure in San Marcos
People who were at Texas State University from approximately 3 to 7 p.m. and Twin Peaks Restaurant from 6 to 10 p.m. on Feb. 14, 2025 may be at risk of developing measles due to exposure.
New coronavirus discovered in Chinese bats: What we know
This new virus reportedly can bind to humans in a comparable manner to the virus that causes COVID-19.
Flu season is peaking in these 13 states, data shows
With flu cases spiking in the U.S., the CDC released new stats for flu activity nationwide. Here are the states with the highest activity.
Texas Measles outbreak 2025: Cases nearly double over past week
Measles cases in Texas have nearly doubled in the past week with an additional 28 cases reported Friday.
What is Simply Pop? Coca-Cola enters the prebiotic soda market
Simply Pop is the latest line of prebiotic sodas to hit the market.
USDA accidentally fired bird flu employees and is now trying to rehire them
The Trump administration is working to “rectify" the termination of several employees over the weekend that were working to combat bird flu, the agency said.
Texas Measles outbreak 2025: 58 cases across 5 counties in 3 weeks
There have been 10 new cases reported since Feb. 14.
Medicaid changes could be coming: Here's what Republicans are considering
Republicans are weighing billions of dollars in cuts to Medicaid, jeopardizing health care coverage. Here’s what’s on the table.
Understanding your heart's calcium score, why it's important
As Heart Awareness Month unfolds, local cardiologist Dr. Khaled Khalaf sheds light on the significance of knowing your heart's calcium score and how testing can be beneficial.